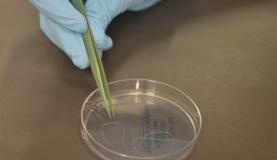
teia

A fabricação de teias de aranha em laboratório é realidade para pesquisadores brasileiros, que, no futuro, podem também fazê-las crescer em plantas.
A pesquisa é desenvolvida na Embrapa Recursos Genéticos e Biotecnologia, em Brasília, e liderada pelo pesquisador Elíbio Rech. Ele explica que a teia de aranha é um produto com alta aplicabilidade comercial e a forma como pode ser produzida define o conceito de sustentabilidade e uso racional da biodiversidade.
“Nós não precisamos mais entrar na floresta para pegar nenhuma aranha. Você vai lá, conhece as propriedades, pega alguns poucos organismos, retira o que precisa e nunca mais volta, você faz sintético. Esse é o caminho real de sustentabilidade, usar a tecnologia para que você não tenha que devastar a floresta para isolar um determinado composto”, disse o pesquisador.
Rech conta o caso da artemisina, produzida pela planta artemísia, um forte componente contra a malária. “Foi feita uma avaliação e começaram a produzir em larga escala, mas foi economicamente inviável porque precisava de áreas enormes. Então, usando a engenharia genética, um grupo da Califórnia produziu em levedura e o composto foi lançado por uma empresa farmacêutica no ano passado. Um produto contra a malária, que veio de uma planta, mas que não precisa mais usar a planta, você faz tudo sintético.”
A pesquisa da Embrapa começou em 2003 com a prospecções na Amazônia, na Mata Atlântica e no Cerrado de aranhas que produzem fibras e o mapeamento genético das glândulas que produzem as proteínas que vão dar origem à seda da teia.
Segundo a pós-doutoranda da Universidade de Brasília (UnB) Valquíria Lacerda, que trabalha no projeto, a criação em laboratório das proteínas da aranha é feita pela bactéria Escherichia coli. “Ainda não existe um organismo ideal para produzir em grande quantidade. Tem pesquisadores que já colocaram em células de mamíferos, de insetos, em bactéria, o mundo inteiro ainda procura uma biofábrica ideal para fazer extração reduzindo o custo desse material”, disse a bióloga.
O passo seguinte consiste na extração das proteínas. Para isso, a massa de bactérias E. Coli é diluída em meio líquido e as proteínas de teia de aranha são resgatadas com uma sequência de DNA específica. Com auxílio de uma seringa especial que simula a espirineta (órgão da aranha que expele a teia), os pesquisadores vão liberando e enrolando a fibra.
“Da última vez, de 100 microlitros, que é a décima parte de um mililitro, conseguimos fazer um fio muito grande, foram mais de 10 metros, rendeu bastante”, contou Valquíria, explicando que as fibras de teia de aranha natural podem variar de 2 a 4 nanômetros e a produzida na Embrapa tem em torno de 40 nanômetros. “De 20 a dez vezes mais espesso do que encontramos na natureza, o que pode ajudar a ser mais forte”, destacando que os próximos passos envolvem testes de extensão e resistência.
Para explicar os possíveis usos dessa fibra, o pesquisador Elíbio Rech faz a comparação com o plástico, ou seja, serve para quase tudo. “É um material novo que tem duas características, flexibilidade e resistência, e também é biodegradável. Ele tem uma característica física que permite um melhor desempenho para tudo.”
Pode ser usado na produção de tecidos, em fios para sutura, para quem tem alergia ao nylon, por exemplo, e também em nanopartículas para o endereçamento preciso de drogas e medicamentos no corpo humano.
Também em composições metálicas e plásticas para placas e peças de aviões e para os cascos de navios. “Qualquer material que dure mais vai reduzir o custo de manutenção. Ao conseguir fazer com que um material trabalhe mais e seja mais leve, você também reduz o gasto de combustível, reduz emissão de gás carbônico na atmosfera, então tem todo um ganho direto e indireto do uso de um material como esse”, disse Rech.
Além das inúmeras aplicações e benefícios para o desenvolvimento de diversos setores da economia, o fato de os estudos serem baseados em aranhas brasileiras permite agregar valor à biodiversidade nacional.
Segundo Rech, a tecnologia da produção de fios de teias de aranha já está dominada. O próximo passo é definir um meio econômico, rápido e seguro para a sua produção em larga escala. “O nosso interesse era juntar as duas coisas, que nós possamos produzir essa fibra, que está sendo feita hoje em bactéria, em uma semente de soja ou em outra planta, de forma a reduzir o custo de produção.”
Os pesquisadores já fizeram testes preliminares para introduzir em plantas, mas precisam de mais pessoas para compor o grupo. “No setor público temos dificuldade em manter os grandes cérebros, as pessoas vêm, ficam um tempo, recebem outras propostas e acabam saindo. Isso não é ideal para o projeto, mas faz parte da formação, o país ganha com isso”, disse Rech.
Para o pesquisador, a empresa pública já cumpriu seu papel de gerar um ativo tecnológico ao produzir essas fibras em bactérias. “Esse é um potencial produto muito importante, agora o setor privado tem que fazer a outra parte, escalonar e transformar isso em um produto comercial. Ainda precisamos reduzir um pouco o custo de produção, nós saberíamos como fazer, também com outro laboratório e equipamentos, mas, como eu disse, faltam pessoas para colaborar com a gente.”
A utilização de plantas, micro-organismos e animais geneticamente modificados como biofábricas é estudada para a produção não apenas desses fios, mas também de medicamentos e outros insumos essenciais à população.
Na Embrapa Recursos Genéticos e Biotecnologia são desenvolvidos estudos em plantas de soja transgênica capazes de produzir o fator 9, uma proteína responsável pela coagulação do sangue. Os hemofílicos não produzem essa proteína e precisam dela para melhorar a sua qualidade de vida.
Também há a soja com gene que estimula o hormônio do crescimento (GHC) e plantas transgênicas para combater a aids. “A soja é uma planta realmente maravilhosa porque é uma semente que tem 40% de proteína e o restante de óleo”, disse Rech. “Você tem uma semente e um sistema de produção fenomenais. É imbatível.”
Segundo a Embrapa, o faturamento da biotecnologia na indústria farmacêutica mundial cresceu muito nas últimas décadas e hoje alcança aproximadamente US$ 10 bilhões ao ano. Os produtos biotecnológicos estão em franco desenvolvimento e hoje alcançam 10% dos novos produtos atualmente no mercado.
Todas essas pesquisas são realizadas em parceria com outras unidades da Embrapa, instituições de pesquisa e universidades do Brasil e do exterior.